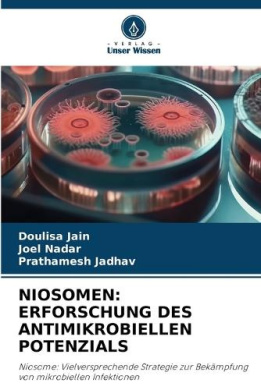
https://raw.githubusercontent.com/stevesteve2020-lab/img/refs/heads/main/8kAoImvmVZQkPK.jpeg

-
-83%

Nervous, Immune, Endocrine Regulatory Systems & Diseases Associated with Nerve Growth Factor Co-Secretion
0Original price was: $69.00.$12.00Current price is: $12.00.Nervous, Immune, Endocrine Regulatory Systems & Diseases Associated with Nerve Growth Factor Co-Secretion, Verne S Caviness, 9781608767809
-
-81%

Network Approaches to Diseases of the Brain
0Original price was: $72.00.$14.00Current price is: $14.00.Network Approaches to Diseases of the Brain, Verne S Caviness, 9781608053803
-
-44%

Neue medicinisch-chirurgische Beobachtungen
0Original price was: $27.00.$15.00Current price is: $15.00.Neue medicinisch-chirurgische Beobachtungen, H A Bardeleben, 9783112628690
-
-83%

Neuroendocrinology Research Developments
0Original price was: $81.00.$14.00Current price is: $14.00.Neuroendocrinology Research Developments, Verne S Caviness, 9781608769834
-
-36%

Neurofeedback: Tools, Methods and Applications
0Original price was: $28.00.$18.00Current price is: $18.00.Neurofeedback: Tools, Methods and Applications, Verne S Caviness, 9781785482762
-
-84%

New York Journal of Medicine.; ser.3: v.5, (1858)
0Original price was: $43.00.$7.00Current price is: $7.00.New York Journal of Medicine.; ser.3: v.5, (1858), Charles a., 9781015337381
-
-85%
Niosomen: Erforschung Des Antimikrobiellen Potenzials
0Original price was: $61.00.$9.00Current price is: $9.00.Niosomen: Erforschung Des Antimikrobiellen Potenzials, , 9786208332174
-
-78%

On the Treatment of Wounds: Clinical Lectures
0Original price was: $68.00.$15.00Current price is: $15.00.On the Treatment of Wounds: Clinical Lectures, Charles a., 9781015344426
-
-87%

Opracowanie i walidacja metody dla preparatu wieloziolowego wprowadzonego do obrotu
0Original price was: $120.00.$16.00Current price is: $16.00.Opracowanie i walidacja metody dla preparatu wieloziolowego wprowadzonego do obrotu, , 9786208318383
-
-83%

Orthopaedic Surgery for Students and General Practitioners: Preliminary Considerations and Diseases of the Spine: 114 Original Illustrations
0Original price was: $47.00.$8.00Current price is: $8.00.Orthopaedic Surgery for Students and General Practitioners: Preliminary Considerations and Diseases of the Spine: 114 Original Illustrations, Charles a., 9781015376878
-
-72%

Pr-drogas mtuas base de curcumina
0Original price was: $65.00.$18.00Current price is: $18.00.Pr-drogas mtuas base de curcumina, , 9786208080631
-
-76%

Profarmaci reciproci a base di curcumina
0Original price was: $58.00.$14.00Current price is: $14.00.Profarmaci reciproci a base di curcumina, , 9786208080679


